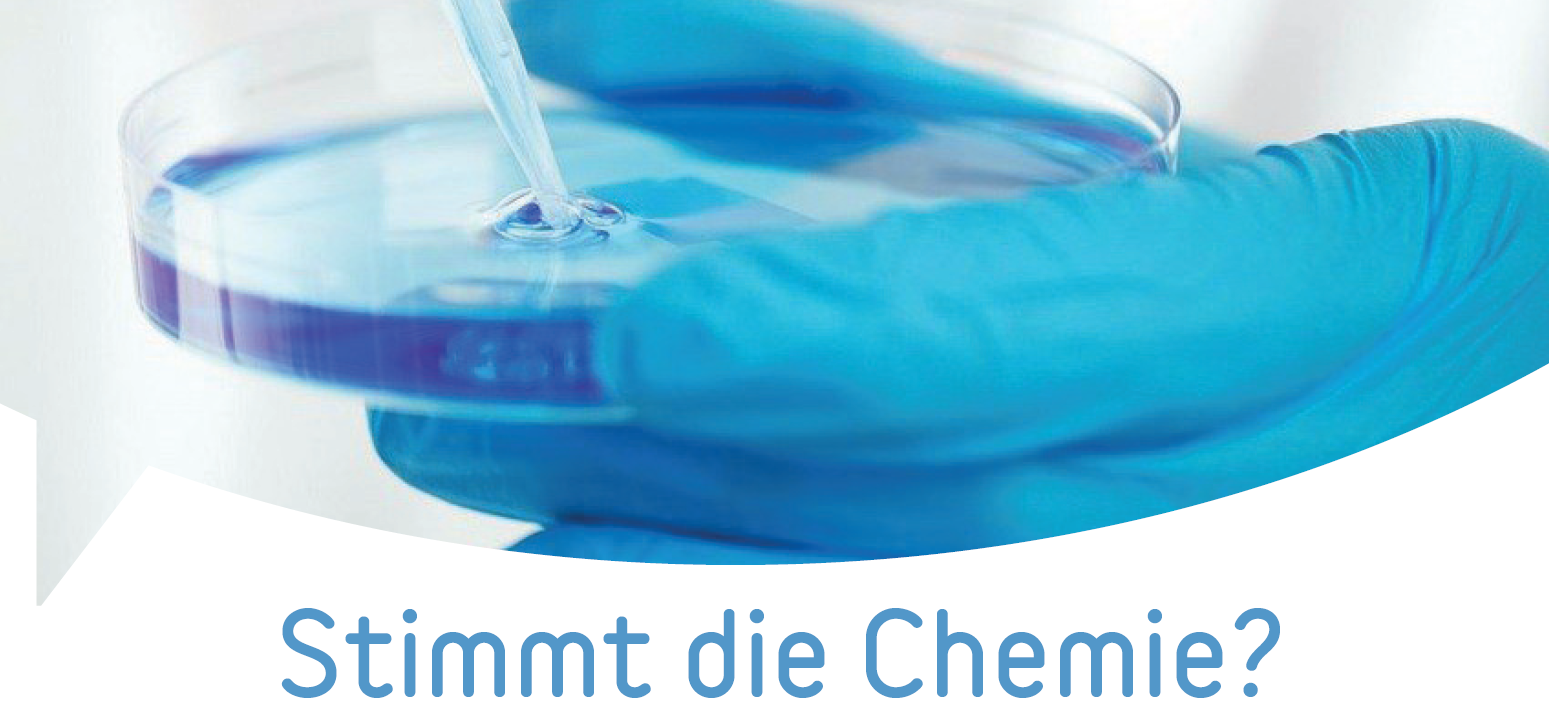

Sie als Medizinisch-technische/r-Laboratoriumsassistent/ in (MTLA) (m/w/d) möchten wissen, ob die Chemie stimmt? Finden Sie es in unserem krankenhauseigenem Labor mit dem neuesten Stand der Technik heraus. Analysen der Hämatologie oder der klinischen Chemie (Endokrinologie, Serologie und Liquordiagnostik) gehören zu den täglichen Anforderungen.
Und dabei haben wir mit dem EKV ein starkes Team im Rücken: Als kirchlicher Träger vereint er das Luisenhospital, unsere Senioreneinrichtung „Ein Zuhause im Alter“ , unsere hauseigene Bildungsakademie sowie verschiedene medizinische Versorgungszentren (MVZ) mit über 1.600 Mitarbeitenden.
Besonders wichtig ist uns die zwischenmenschliche Chemie! Wir sind ein zehnköpfiges Team mit Spaß an der Arbeit, das sich darauf freut, Sie kennenzulernen!
Bewerben Sie sich jetzt über unser Online-Formular:





